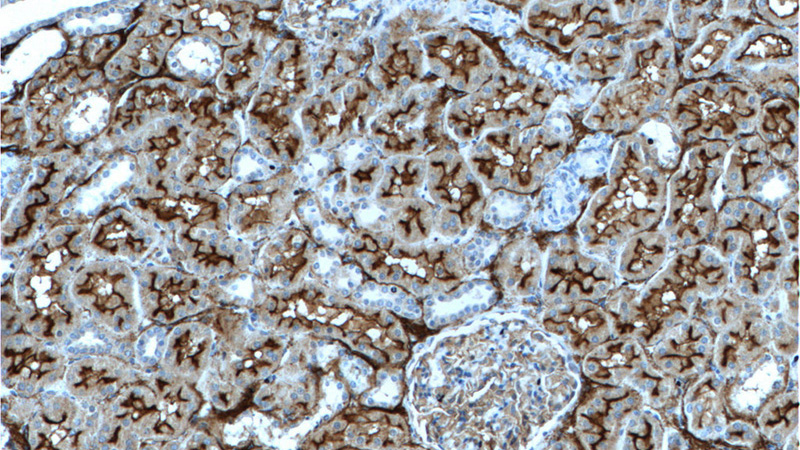
Immunohistochemistry of paraffin-embedded human kidney tissue slide using Catalog No:109039(CD10,MME Antibody) at dilution of 1:200 (under 10x lens)
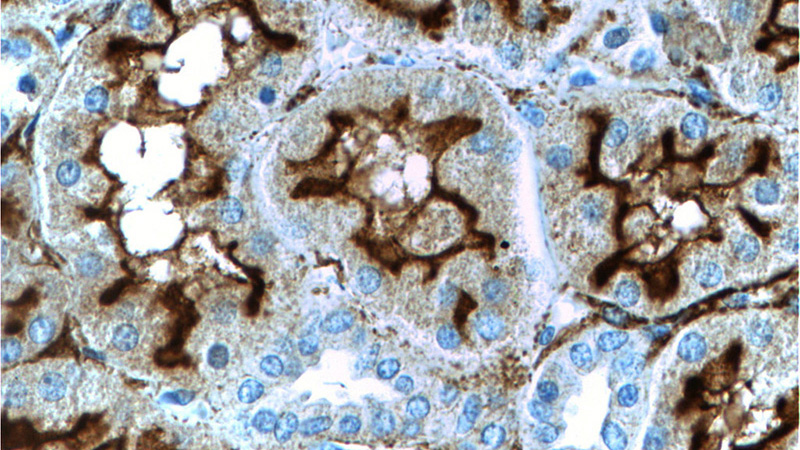
Immunohistochemistry of paraffin-embedded human kidney tissue slide using Catalog No:109039(CD10,MME Antibody) at dilution of 1:200 (under 40x lens)

-
Product Name
CD10,MME antibody
- Documents
-
Description
CD10,MME Rabbit Polyclonal antibody. Positive IHC detected in human kidney tissue, human renal cell carcinoma tissue. Positive FC detected in Jurkat cells.
-
Tested applications
ELISA, FC, IHC
-
Species reactivity
Human; other species not tested.
-
Alternative names
Atriopeptidase antibody; CALLA antibody; CD10 antibody; DKFZp686O16152 antibody; Enkephalinase antibody; EPN antibody; membrane metallo endopeptidase antibody; MME antibody; NEP antibody; Neprilysin antibody; Neutral endopeptidase antibody; Neutral endopeptidase 24.11 antibody
-
Isotype
Rabbit IgG
-
Preparation
This antibody was obtained by immunization of CD10,MME recombinant protein (Accession Number: XM_011512857). Purification method: Antigen affinity purified.
-
Clonality
Polyclonal
-
Formulation
PBS with 0.02% sodium azide and 50% glycerol pH 7.3.
-
Storage instructions
Store at -20℃. DO NOT ALIQUOT
-
Applications
Recommended Dilution:
IHC: 1:20-1:200
-
Validations
Immunohistochemistry of paraffin-embedded human kidney tissue slide using Catalog No:109039(CD10,MME Antibody) at dilution of 1:200 (under 10x lens)
Immunohistochemistry of paraffin-embedded human kidney tissue slide using Catalog No:109039(CD10,MME Antibody) at dilution of 1:200 (under 40x lens)

1X10^6 Jurkat cells were stained with 0.5ug CD10,MME antibody (Catalog No:109039, red) and control antibody (blue). Fixed with 90% MeOH blocked with 3% BSA (30 min). Alexa Fluor 488-congugated AffiniPure Goat Anti-Rabbit IgG(H+L) with dilution 1:1000.
-
Background
MME is also names as neprilysin,CALLA,NEP,SFE,CD10 and belongs to the peptidase M13 family.It is a glycoprotein that is particularly abundant in kidney, where it is present on the brush border of proximal tubules and on glomerular epithelium.CD10 has been considered a useful marker in the diagnosis of renal carcinomas, because of its expression in clear cell and papillary renal cell carcinomas and its absence in chromophobe renal cell carcinomas(PMID:15286660).
Related Products / Services
Please note: All products are "FOR RESEARCH USE ONLY AND ARE NOT INTENDED FOR DIAGNOSTIC OR THERAPEUTIC USE"
